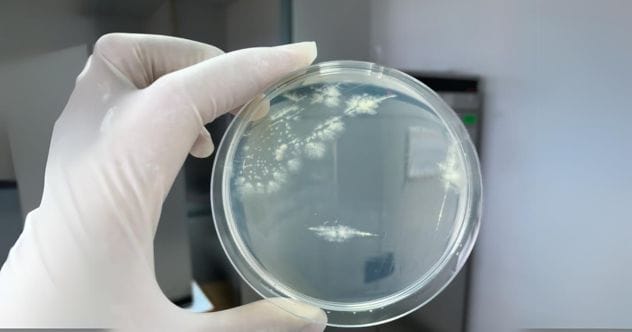
Microbial Art: 10 Cool Facts About Bacteria Paintings

It’s fascinating to see how microbial art, also known as agar art, stands out from other art forms. The medium involves living organisms, and the canvas is a petri dish. These creations were initially grown by scientists but are now accessible to the public through workshops and kits.
The result is a collection of vibrant images that are both attractive and educational. However, safety is important, requiring careful procedures like destroying the “germ paintings” after creation.
While some worry about the risks for amateurs, others believe mixing art and science can unite people. Let’s explore the world of painting with bacteria.
10. The Necessary Materials
Like traditional painting, microbial art needs specific materials. These include a tool (paintbrush, stick, or platinum loop), live bacteria strains, nutrient-enriched antibiotic powder, and agar. Agar, derived from red algae, is used for thickening and stabilizing. When combined with nutrients, it creates a solid surface for bacteria to grow, study, or be used to create art.
Agar art uses this jelly-like medium to culture pigmented microbes and manipulate them into elaborate designs, blending art and science.
![]()
9. Painting with Bacteria
Painting microbial art involves two simple steps that are far from easy.
First, mix agar and nutrient-enriched antibiotic powder (peptone, yeast extract, and sodium chloride) with water in a glass jar. Sterilize the mixture in an autoclave for 30 minutes at 250°F (121°C). Pour the hot agar into a petri dish, cover, and let it solidify for one hour. Then, turn it upside down to dry for 24 hours.
Next, add bacteria strains to a sterilized loop (brush or stick) and paint onto the agar. Colors appear after a day, so a sketch is often placed under the dish for tracing. Allow the dish to dry, seal, and place in an incubator for 24 hours, then at room temperature for 48 hours. (Times vary based on bacteria.) A photo completes the process.
![]()
8. Colorful Bacteria
Microbial art can be unpredictable. Bacteria may release chemicals that hinder color production from other bacteria. It’s important to know how bacteria interact. Some scientists genetically engineer microbes for better control over colors, while others add powdered charcoal to the agar for a black background.
Frederick Hammes, a microbiologist, creates 3D agar art that rises off the petri dish like a sculpture.
![]()
7. There Are Risks Involved
Microbial art can be dangerous if not handled correctly. Pathogens, disease-causing bacteria, pose risks, including contamination. Less than 1% of microbes are harmful, but those pathogens can be deadly.
Microbes can cause infectious diseases, chronic diseases, cancer, and heart disease. Examples include the common cold, chickenpox, tuberculosis, flu, malaria, and pneumonia.
![]()
6. Microbial Art Has an Expiration Date
Bacteria colors emerge after 24-48 hours and remain vibrant for months. Once the colors fade, the artwork must be disposed of in an autoclave, which uses pressurized steam to kill the bacteria. This prevents antibiotics from entering the environment and causing antibiotic resistance.
Strict safety measures include wearing a lab coat, eyewear, and gloves. Open-toed shoes are prohibited, and bleach spray bottles are essential. These safety protocols raise concerns about amateur microbiologists.
![]()
5. The Father of Microbial Art
Scottish bacteriologist Alexander Fleming (1881–1955) is credited with developing microbial art, which led to penicillin’s discovery. As an amateur watercolor painter, Fleming experimented with microbes. He found joy in discovering new strains and adding bacteria to his palette.
Fleming noticed a “lighter body” on one of his creations, where bacteria were dying. This was the Penicillium fungus, which produces penicillin, the world’s first antibiotic.
![]()
4. An Annual Agar Art Contest
The American Society of Microbiology (ASM) held the first microbial art contest in 2015. Winners have created images of peacocks, dandelions, and microbiologist portraits, all from microbes.
The contest is open to everyone, including kids. Community labs offer art workshops with bioengineered microbes, and at-home kits are available. Winners receive cash prizes and have their art displayed on the ASM’s website.
![]()
3. Bacteria Are Better Than They Seem
The Agar Art contest aims to show the beauty and diversity of microbes. Microbiologist David Westenberg notes that most people see bacteria as bad, but most are harmless and beneficial.
Westenberg believes this art form can unite people by providing understanding and respect for these organisms.
![]()
2. Merging Science and Art
Microbial art turns scientists into artists. Maria Peñil Cobo, a mixed-media artist, learned to grow colorful bacteria and paint microbes under Mehmet Berkman’s instruction.
Peñil often gets inspiration from nature but also uses bacteria from her lips or house key. Peñil and Berkman won first place in the 2015 Agar Art competition. Berkman describes the relationship microbial art creates between science and art.
![]()
1. Endless Possibilities
Contest winners often feature themes of science, space, nature, and animals, but microbes allow for diverse artwork. Microbial art includes reproductions of famous paintings, such as Van Gogh’s The Starry Night and portraits, such as Ruth Bader Ginsberg.
Other creations are purely fun, like Valentine’s themed art or glow-in-the-dark art with bioluminescent bacteria. Agar art sends a powerful message about microbes, promoting respect for these organisms.
![]()
Microbial art is an innovative blend of science and art with the potential to change how we see the microscopic world. From the necessary safety precautions to the endless creative possibilities, this unique art form offers something for everyone.
Leave your comment below and share which fact about microbial art surprised you the most!